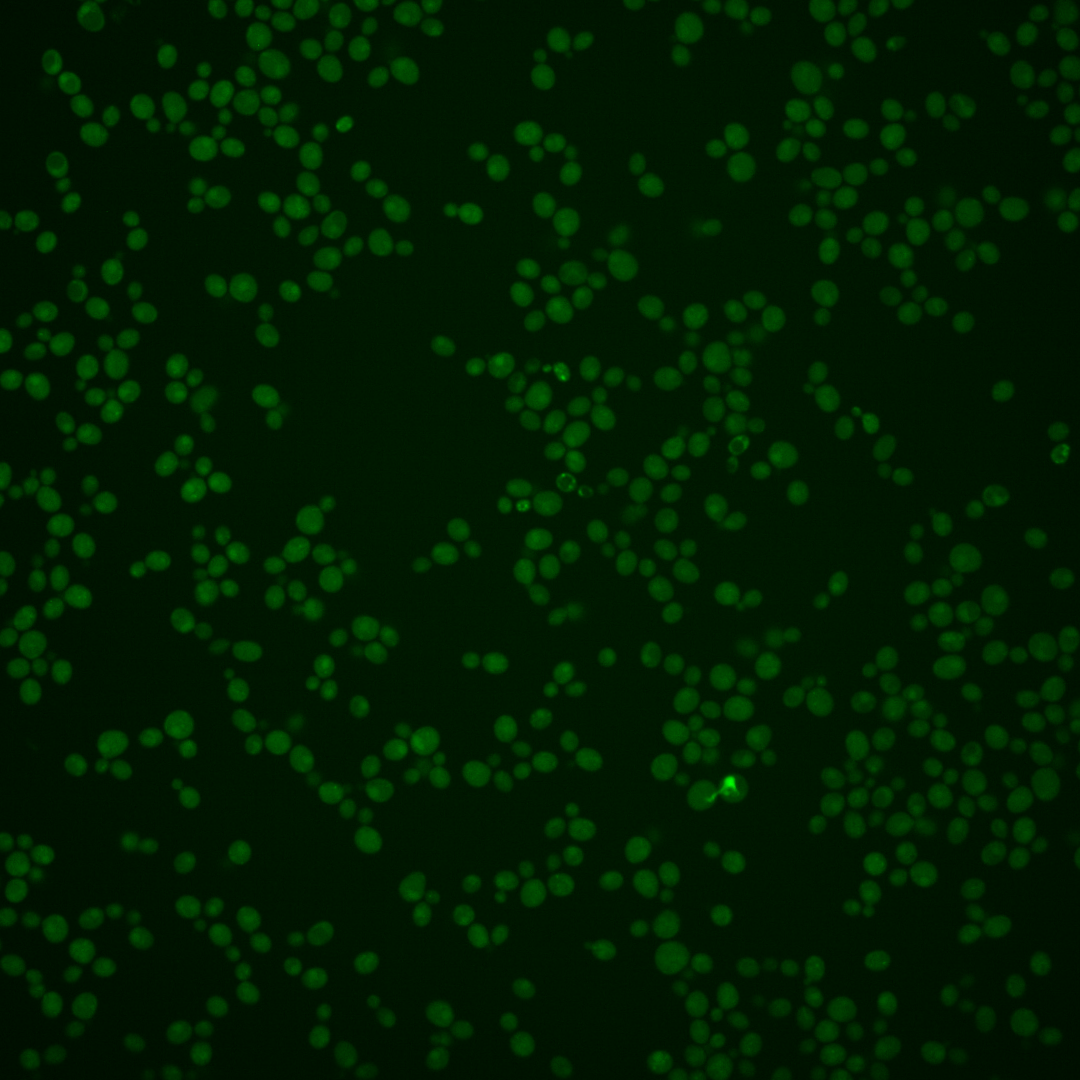
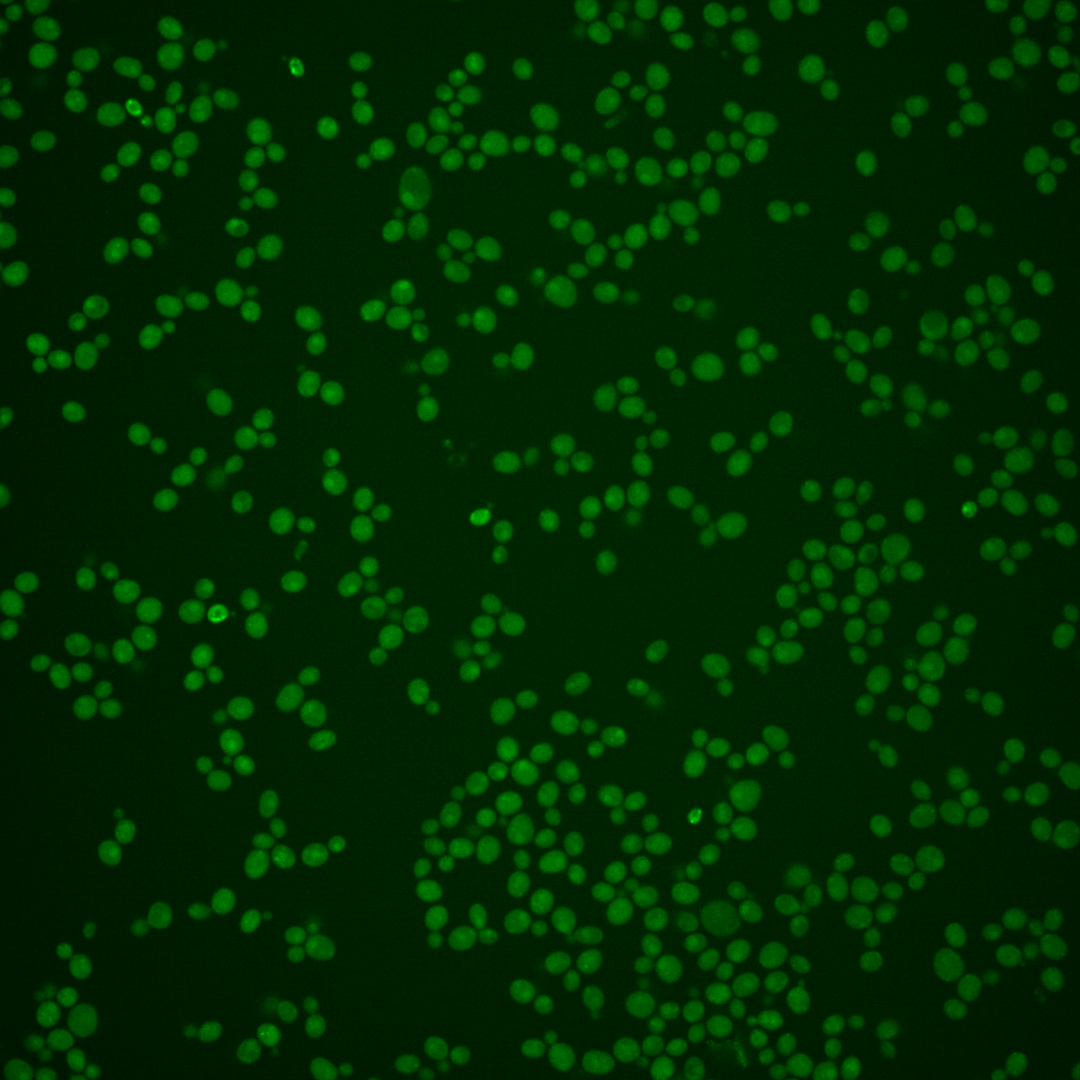
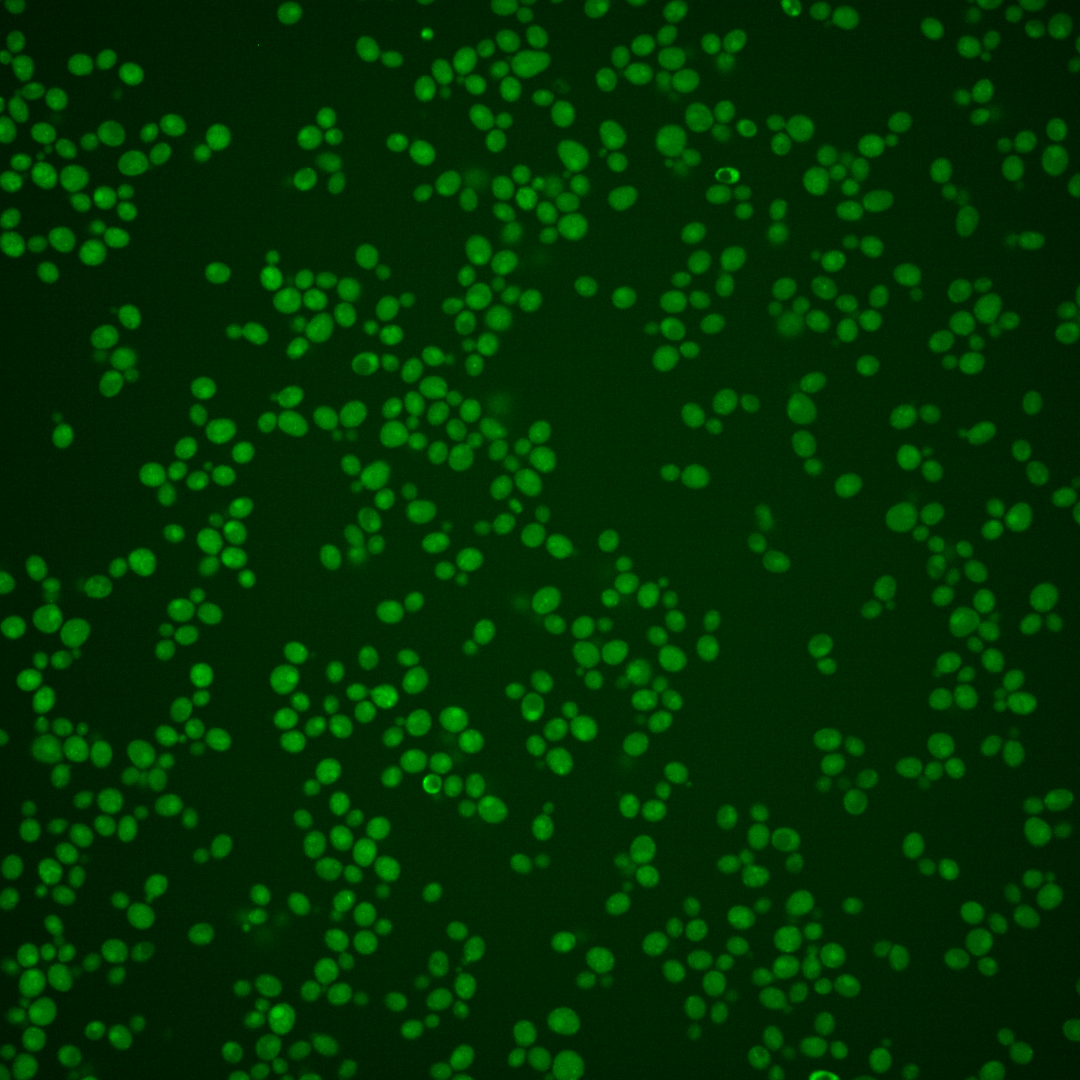

| Standard name | |
|---|---|
| Human Ortholog | |
| Description | Non-essential INO80 chromatin remodeling complex subunit; preferentially binds DNA ends, protecting them from exonucleatic cleavage; deletion affects telomere maintenance via recombination; related to mammalian high mobility group proteins |
Micrographs




















































































Sub-cellular Localization
Yeast GFP Assignment
Protein Abundance
Localization Change
External localization resources
| ensLOC | DeepLoc | |||||||||||||||||||||||
|---|---|---|---|---|---|---|---|---|---|---|---|---|---|---|---|---|---|---|---|---|---|---|---|---|
| Localization | WT1 | WT2 | WT3 | RAP60 | RAP140 | RAP220 | RAP300 | RAP380 | RAP460 | RAP540 | RAP620 | RAP700 | HU80 | HU120 | HU160 | rpd3Δ_1 | rpd3Δ_2 | rpd3Δ_3 | WT1 | WT2 | WT3 | AF100 | AF140 | AF180 |
| Cortical Patches | 0 | 0 | 0 | 0 | 0 | 0 | 0 | – | 0 | 0 | 0 | 0 | 0 | 0 | 0 | 0 | 0 | 1 | 0 | 3 | 0 | 0 | 1 | 2 |
| Bud | 0 | 0 | 0 | 0 | 0 | 0 | 0 | – | 4 | 5 | 0 | 1 | 0 | 0 | 0 | 0 | 0 | 1 | 4 | 3 | 2 | 1 | 5 | 4 |
| Bud Neck | 0 | 0 | 0 | 0 | 0 | 0 | 0 | – | 0 | 0 | 0 | 0 | 0 | 0 | 0 | 0 | 0 | 0 | 0 | 2 | 0 | 0 | 1 | 0 |
| Bud Site | 0 | 0 | 0 | 0 | 0 | 0 | 0 | – | 0 | 0 | 0 | 0 | 0 | 0 | 0 | 0 | 0 | 0 | – | – | – | – | – | – |
| Cell Periphery | 0 | 0 | 0 | 0 | 0 | 0 | 0 | – | 0 | 1 | 0 | 0 | 0 | 0 | 0 | 0 | 0 | 0 | 0 | 0 | 0 | 0 | 0 | 0 |
| Cytoplasm | 79 | 161 | 108 | 144 | 147 | 134 | 243 | – | 330 | 374 | 152 | 240 | 131 | 308 | 374 | 68 | 53 | 61 | 5 | 20 | 9 | 16 | 28 | 27 |
| Endoplasmic Reticulum | 1 | 5 | 1 | 0 | 0 | 1 | 0 | – | 0 | 0 | 0 | 0 | 2 | 2 | 0 | 29 | 12 | 19 | 0 | 1 | 0 | 1 | 1 | 3 |
| Endosome | 39 | 3 | 4 | 4 | 2 | 0 | 3 | – | 1 | 2 | 1 | 1 | 7 | 10 | 1 | 8 | 10 | 7 | 15 | 10 | 2 | 4 | 18 | 19 |
| Golgi | 0 | 0 | 0 | 0 | 0 | 0 | 0 | – | 0 | 0 | 0 | 0 | 0 | 1 | 0 | 8 | 2 | 3 | 2 | 0 | 1 | 0 | 1 | 0 |
| Mitochondria | 63 | 33 | 1 | 4 | 3 | 30 | 2 | – | 20 | 22 | 21 | 14 | 0 | 2 | 0 | 12 | 2 | 18 | 9 | 10 | 1 | 5 | 10 | 11 |
| Nucleus | 64 | 34 | 13 | 18 | 19 | 23 | 8 | – | 5 | 4 | 0 | 3 | 1 | 0 | 1 | 168 | 100 | 140 | 20 | 2 | 0 | 1 | 1 | 2 |
| Nuclear Periphery | 1 | 1 | 0 | 0 | 2 | 2 | 4 | – | 1 | 2 | 3 | 4 | 0 | 0 | 1 | 1 | 0 | 3 | 2 | 0 | 0 | 1 | 2 | 3 |
| Nucleolus | 10 | 0 | 0 | 0 | 0 | 1 | 0 | – | 0 | 0 | 0 | 0 | 0 | 0 | 0 | 0 | 0 | 1 | 4 | 0 | 0 | 0 | 1 | 0 |
| Peroxisomes | 2 | 1 | 0 | 0 | 0 | 0 | 0 | – | 0 | 0 | 0 | 0 | 0 | 0 | 0 | 0 | 0 | 0 | 0 | 0 | 0 | 0 | 0 | 0 |
| SpindlePole | 1 | 0 | 0 | 1 | 0 | 0 | 1 | – | 0 | 2 | 0 | 0 | 0 | 0 | 0 | 0 | 0 | 1 | 3 | 4 | 1 | 1 | 2 | 2 |
| Vac/Vac Membrane | 312 | 233 | 87 | 90 | 117 | 84 | 117 | – | 74 | 68 | 29 | 33 | 47 | 43 | 26 | 231 | 230 | 193 | 394 | 347 | 175 | 190 | 339 | 240 |
| Unique Cell Count | 441 | 377 | 175 | 199 | 239 | 220 | 307 | 385 | 424 | 178 | 266 | 167 | 337 | 391 | 413 | 330 | 357 | 466 | 412 | 197 | 229 | 418 | 322 | |
| Labelled Cell Count | 572 | 471 | 214 | 261 | 290 | 275 | 378 | 435 | 480 | 206 | 296 | 188 | 366 | 403 | 525 | 409 | 448 | 466 | 412 | 197 | 229 | 418 | 322 | |
Yeast GFP Assignment
Protein Abundance
| Screen | WT1 | WT2 | WT3 | RAP60 | RAP140 | RAP220 | RAP300 | RAP380 | RAP460 | RAP540 | RAP620 | RAP700 | HU80 | HU120 | HU160 | rpd3Δ_1 | rpd3Δ_2 | rpd3Δ_3 | AF100 | AF140 | AF180 |
|---|---|---|---|---|---|---|---|---|---|---|---|---|---|---|---|---|---|---|---|---|---|
| Mean Cell GFP Intensity (1e-4) | 5.2 | 4.9 | 5.6 | 5.7 | 6.1 | 4.3 | 5.4 | – | 4.6 | 4.7 | 4.5 | 4.6 | 5.3 | 5.3 | 5.1 | 7.8 | 8.2 | 7.0 | 4.9 | 5.1 | 5.2 |
| Std Deviation (1e-4) | 1.5 | 1.3 | 1.9 | 2.1 | 1.4 | 1.2 | 1.6 | – | 1.2 | 1.0 | 1.4 | 1.0 | 1.1 | 1.7 | 1.2 | 2.3 | 2.3 | 2.0 | 1.7 | 1.7 | 1.7 |
| Intensity Change (Log2) | – | – | – | 0.04 | 0.12 | -0.38 | -0.05 | – | -0.3 | -0.26 | -0.3 | -0.28 | -0.09 | -0.08 | -0.14 | 0.48 | 0.55 | 0.31 | -0.2 | -0.13 | -0.12 |
Localization Change
| Localization | RAP60 | RAP140 | RAP220 | RAP300 | RAP380 | RAP460 | RAP540 | RAP620 | RAP700 | HU80 | HU120 | HU160 | rpd3Δ_1 | rpd3Δ_2 | rpd3Δ_3 |
|---|---|---|---|---|---|---|---|---|---|---|---|---|---|---|---|
| Actin | – | – | – | – | – | – | – | – | – | – | – | – | – | – | – |
| Bud | – | – | – | – | – | – | – | – | – | – | – | – | 0 | 0 | 0 |
| Bud Neck | – | – | – | – | – | – | – | – | – | – | – | – | 0 | 0 | 0 |
| Bud Site | – | – | – | – | – | – | – | – | – | – | – | – | 0 | 0 | 0 |
| Cell Periphery | – | – | – | – | – | – | – | – | – | – | – | – | 0 | 0 | 0 |
| Cyto | – | – | – | – | – | – | – | – | – | – | – | – | – | – | – |
| Endoplasmic Reticulum | – | – | – | – | – | – | – | – | – | – | – | – | 0 | 0 | 0 |
| Endosome | – | – | – | – | – | – | – | – | – | – | – | – | 0 | 0 | 0 |
| Golgi | – | – | – | – | – | – | – | – | – | – | – | – | 0 | 0 | 0 |
| Mitochondria | – | – | – | – | – | – | – | – | – | – | – | – | 0 | 0 | 0 |
| Nuclear Periphery | – | – | – | – | – | – | – | – | – | – | – | – | 0 | 0 | 0 |
| Nuc | – | – | – | – | – | – | – | – | – | – | – | – | – | – | – |
| Nucleolus | – | – | – | – | – | – | – | – | – | – | – | – | 0 | 0 | 0 |
| Peroxisomes | – | – | – | – | – | – | – | – | – | – | – | – | 0 | 0 | 0 |
| SpindlePole | – | – | – | – | – | – | – | – | – | – | – | – | 0 | 0 | 0 |
| Vac | – | – | – | – | – | – | – | – | – | – | – | – | – | – | – |
| Cortical Patches | – | – | – | – | – | – | – | – | – | – | – | – | 0 | 0 | 0 |
| Cytoplasm | – | – | – | – | – | – | – | – | – | – | – | – | 0 | 0 | 0 |
| Nucleus | – | – | – | – | – | – | – | – | – | – | – | – | 0 | 0 | 0 |
| Vacuole | – | – | – | – | – | – | – | – | – | – | – | – | 1.4 | 4.4 | 0.9 |
External localization resources
Images






























Protein Concentration and Protein Localization Data
| R1 | R2 | R3 | ||||||||||||||||
|---|---|---|---|---|---|---|---|---|---|---|---|---|---|---|---|---|---|---|
| G1 Pre-START | G1 Post-START | S/G2 | Metaphase | Anaphase | Telophase | G1 Pre-START | G1 Post-START | S/G2 | Metaphase | Anaphase | Telophase | G1 Pre-START | G1 Post-START | S/G2 | Metaphase | Anaphase | Telophase | |
| Concentration | 0.51 | 0.4761 | -0.0241 | 0.1622 | -0.1658 | 0.0212 | 1.6376 | 3.0224 | 2.3813 | 2.1447 | 2.752 | 2.2934 | 3.2309 | 4.8031 | 3.4926 | 3.9845 | 2.7828 | 3.8843 |
| Actin | 0.0318 | 0.0003 | 0 | 0.0243 | 0.0001 | 0 | 0.0058 | 0.0002 | 0.0005 | 0.0003 | 0.0016 | 0.0007 | 0.0067 | 0 | 0.0003 | 0 | 0 | 0.0003 |
| Bud | 0.0009 | 0.0007 | 0.0002 | 0.0014 | 0.0005 | 0.0003 | 0.001 | 0.001 | 0.0012 | 0.0009 | 0.0007 | 0.001 | 0.0005 | 0.0126 | 0.0008 | 0.0007 | 0.0007 | 0.0006 |
| Bud Neck | 0.0044 | 0.0015 | 0.0007 | 0.0014 | 0.0016 | 0.0021 | 0.0015 | 0.0022 | 0.003 | 0.0012 | 0.0011 | 0.0024 | 0.0024 | 0.0014 | 0.0012 | 0.0026 | 0.0016 | 0.0024 |
| Bud Periphery | 0.0011 | 0.001 | 0.0006 | 0.0022 | 0.0016 | 0.0008 | 0.0023 | 0.0022 | 0.0029 | 0.0028 | 0.0018 | 0.0035 | 0.0013 | 0.0136 | 0.0029 | 0.0014 | 0.0014 | 0.0018 |
| Bud Site | 0.0048 | 0.0062 | 0.0007 | 0.0098 | 0.0016 | 0.0006 | 0.0063 | 0.0025 | 0.0041 | 0.0013 | 0.0013 | 0.0013 | 0.0027 | 0.003 | 0.0021 | 0.0053 | 0.0029 | 0.0011 |
| Cell Periphery | 0.0016 | 0.0019 | 0.0011 | 0.0005 | 0.0011 | 0.0012 | 0.0013 | 0.0024 | 0.0025 | 0.0009 | 0.0012 | 0.0021 | 0.0042 | 0.0017 | 0.0016 | 0.0017 | 0.0009 | 0.0024 |
| Cytoplasm | 0.0227 | 0.0288 | 0.0311 | 0.0492 | 0.0235 | 0.0336 | 0.0198 | 0.0173 | 0.0125 | 0.0043 | 0.0122 | 0.0106 | 0.0228 | 0.0211 | 0.0176 | 0.0101 | 0.0167 | 0.0205 |
| Cytoplasmic Foci | 0.03 | 0.0372 | 0.0287 | 0.0144 | 0.0515 | 0.0351 | 0.0302 | 0.0154 | 0.0259 | 0.019 | 0.034 | 0.0211 | 0.0252 | 0.0133 | 0.037 | 0.0094 | 0.0695 | 0.0264 |
| Eisosomes | 0.0003 | 0.0001 | 0 | 0.0002 | 0.0001 | 0 | 0 | 0 | 0.0001 | 0 | 0 | 0 | 0.0002 | 0 | 0.0001 | 0 | 0.0001 | 0 |
| Endoplasmic Reticulum | 0.0086 | 0.0039 | 0.0035 | 0.0027 | 0.002 | 0.003 | 0.0057 | 0.0042 | 0.0035 | 0.0011 | 0.0029 | 0.002 | 0.0051 | 0.0036 | 0.0024 | 0.0014 | 0.0013 | 0.0033 |
| Endosome | 0.2111 | 0.2359 | 0.2426 | 0.4244 | 0.3659 | 0.2688 | 0.2878 | 0.1627 | 0.2719 | 0.2339 | 0.255 | 0.2479 | 0.3092 | 0.202 | 0.3149 | 0.2256 | 0.4069 | 0.2829 |
| Golgi | 0.0289 | 0.0066 | 0.0068 | 0.0175 | 0.0119 | 0.0056 | 0.0104 | 0.0037 | 0.0069 | 0.0062 | 0.0116 | 0.007 | 0.0072 | 0.0038 | 0.007 | 0.0047 | 0.009 | 0.0059 |
| Lipid Particles | 0.0209 | 0.0255 | 0.0231 | 0.0202 | 0.0818 | 0.0245 | 0.0267 | 0.0095 | 0.0148 | 0.0173 | 0.0137 | 0.0132 | 0.0194 | 0.0128 | 0.0146 | 0.0292 | 0.0201 | 0.0187 |
| Mitochondria | 0.0303 | 0.032 | 0.051 | 0.0181 | 0.017 | 0.0138 | 0.0172 | 0.0132 | 0.023 | 0.0215 | 0.0133 | 0.0068 | 0.0175 | 0.0079 | 0.0312 | 0.037 | 0.0162 | 0.0207 |
| None | 0.0576 | 0.0181 | 0.0565 | 0.004 | 0.0486 | 0.0639 | 0.0144 | 0.0039 | 0.0236 | 0.0015 | 0.0103 | 0.0097 | 0.041 | 0.021 | 0.0581 | 0.0009 | 0.0053 | 0.022 |
| Nuclear Periphery | 0.0172 | 0.0083 | 0.008 | 0.0056 | 0.0018 | 0.0069 | 0.0094 | 0.0124 | 0.0067 | 0.0023 | 0.0159 | 0.0055 | 0.0077 | 0.003 | 0.0047 | 0.0018 | 0.0017 | 0.0056 |
| Nucleolus | 0.0033 | 0.0064 | 0.0035 | 0.0011 | 0.0016 | 0.0039 | 0.0074 | 0.0082 | 0.0117 | 0.0032 | 0.0037 | 0.0072 | 0.0089 | 0.0054 | 0.0059 | 0.0053 | 0.0232 | 0.0033 |
| Nucleus | 0.0068 | 0.0055 | 0.0065 | 0.0256 | 0.0018 | 0.0063 | 0.0162 | 0.0106 | 0.0144 | 0.0041 | 0.0091 | 0.0137 | 0.0088 | 0.0061 | 0.0164 | 0.0042 | 0.0185 | 0.0064 |
| Peroxisomes | 0.0107 | 0.0015 | 0.0016 | 0.0042 | 0.0222 | 0.0029 | 0.0055 | 0.0009 | 0.0039 | 0.0159 | 0.0069 | 0.004 | 0.0024 | 0.0013 | 0.0035 | 0.0022 | 0.0042 | 0.0034 |
| Punctate Nuclear | 0.0038 | 0.0009 | 0.0006 | 0.0017 | 0.0006 | 0.0007 | 0.0016 | 0.0003 | 0.0011 | 0.0005 | 0.0108 | 0.0013 | 0.0029 | 0.0004 | 0.0008 | 0.0002 | 0.0019 | 0.0012 |
| Vacuole | 0.3951 | 0.4559 | 0.4057 | 0.2587 | 0.3163 | 0.4327 | 0.4293 | 0.6037 | 0.4525 | 0.5701 | 0.5007 | 0.5226 | 0.431 | 0.5866 | 0.3878 | 0.5552 | 0.354 | 0.4831 |
| Vacuole Periphery | 0.1081 | 0.1219 | 0.1276 | 0.1127 | 0.0467 | 0.0932 | 0.1002 | 0.1236 | 0.1133 | 0.0916 | 0.0919 | 0.1163 | 0.0731 | 0.0793 | 0.0891 | 0.1011 | 0.044 | 0.0879 |
Sequencing Data
| R1 | R2 | |||||||||
|---|---|---|---|---|---|---|---|---|---|---|
| G1 Post-START | S/G2 | Metaphase | Anaphase | Telophase | G1 Post-START | S/G2 | Metaphase | Anaphase | Telophase | |
| Gene Expression | 21.6354 | 24.1759 | 38.271 | 23.325 | 26.8824 | 46.8507 | 23.222 | 25.8472 | 41.3372 | 24.5386 |
| Translational Efficiency | 1.9806 | 1.6774 | 0.8918 | 1.9722 | 1.3737 | 0.9555 | 1.6901 | 1.5021 | 0.9998 | 1.4985 |
Hit Data
| Dataset | Hit |
|---|---|
| Protein Concentration | ✘ |
| Protein Localization | ✘ |
| Gene Expression | ✘ |
| Translational Efficiency | ✘ |
Endocytosis
| Temp | Actin Patch (Sac6-tdTomato) | Cortical Patch (Sla1-GFP) | Late Endosome (Snf7-GFP) | Vacuole (Vph1-GFP) |
|---|---|---|---|---|
| 37℃ | ||||
| RT |
Cell Cycle Omics
CYCLoPs (Nhp10-GFP)
| Gene / Allele | Actin Patch (Sac6-tdTomato) | Cortical Patch (Sla1-GFP) | Late Endosome (Snf7-GFP) | Vacuole (Sac6-tdTomato) |
|---|
| Gene | Images |
|---|
| Gene | Images |
|---|
Images are not yet available
Images are not yet available